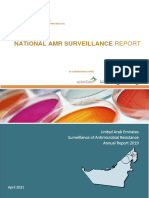

Adult Health History
Chart #: ________________
Name: _________________________________________________ Date: __________________________
What is your impression of your overall health? (circle one) Excellent Good Fair Poor
Age ________ years Height ______ inches Weight _______ pounds
Gender: ___ Male ___ Female ___ Other Preferred pronouns: _______________
Have you had or have you ever experienced any of the following conditions?
Mark all that apply to you, mark “NO” if the boxes in the section do not apply to you.
Please describe any indicated conditions.
Allergies
___ NO allergies or sensitivities of any kind
___ Allergy to latex
___ Allergy to medications
___ Allergy to food
___ Other allergies
If indicated above, please describe: _____________________________________________________________
Breathing or Sleeping Problems
___ NO breathing or sleeping issues
___ Asthma
___ Bronchitis
___ COPD
___ Shortness of breath
___ Productive cough
___ Recent upper respiratory infection
___ O2 (oxygen) dependence
___ Seasonal allergies
___ Sleep apnea
___ Snoring
___ Stops breathing during sleep
___ Daytime sleepiness
___ Awakens more than twice during the night
___ Other breathing or sleeping issues
If indicated above, please describe: _____________________________________________________________
Heart or Circulation Problems
___ NO heart or circulation problems
___ High blood pressure
___ Heart pain/Angina
___ Heart attack
___ Heart failure/Congestive heart failure
___ Irregular heart beat/Arrhythmia
___ Heart surgery
___ Heart murmur
___ Poor exercise tolerance
___ Pacemaker/Defibrillator
___ High cholesterol
___ Other heart or circulation problems
If indicated above, please describe: _____________________________________________________________
1
� Adult Health History
Chart #: ________________
Stomach or Digestion Problems
___ NO gastro intestinal problems
___ Gastric reflux / Heartburn
___ Stomach ulcer / PUD
___ Hiatal hernia
___ Liver disease / Liver cirrhosis
___ Frequent vomiting
If indicated above, please describe: _____________________________________________________________
Chronic Infectious Disease(s)
___ NO chronic infectious disease
___ HIV, CD4/T‐cell count: _______________ Viral load: _________________
___ TB
___ MRSA or VRSA
___ Hepatitis B
___ Hepatitis C
___ Oral HPV
___ Cold sores/Fever blisters
If indicated above, please describe: _____________________________________________________________
Hormone or Kidney Problems
___ NO endocrine or renal problems
___ Diabetes, Last HbA1c: ___________________________ Last Blood Glucose: _________________________
___ Kidney disease / Kidney failure, dialysis schedule: _______________________________________________
___ Kidney dialysis, dialysis schedule: ____________________________________________________________
___ Kidney/Gall stones
___ Thyroid disease
___ Obesity
___ Other hormonal problems
If indicated above, please describe: _____________________________________________________________
Mental Health Problems
___ NO mental health problems
___ Psychiatric history
___ Depression or anxiety
___ Treatment for current psychiatric condition(s).
If indicated above, please describe: _____________________________________________________________
Brain or Nerve Problems
___ NO neurological problems
___ Stroke / Cerebrovascular accident
___ TIA
___ Seizures / Epilepsy
___ Headache/ Migraines
___ Multiple sclerosis
___ Other neurological problems
If indicated above, please describe: _____________________________________________________________
Transplant(s) or Autoimmune Problems
___ NO transplant or autoimmune concerns
___ Arthritis
___Joint replacement:
When? _____________________ What Kind? ____________________________________
2
� Adult Health History
Chart #: ________________
___ Sjogren’s syndrome
___ Autoimmune disease
___ Organ transplant: When? __________________ What Kind? _______________________________________
___ Other ___________________________________________________________________________________
If indicated above, please describe: _____________________________________________________________
Blood (Hematologic problems)
___ NO hematologic problems
___ Anemia
___Clotting disorder
___ Excessive bleeding following surgery
___ Anticoagulation / Blood thinners, Last INR? ____________________________________________________
___ Atrial fibrillation (A‐fib), Last INR or other treatment? ___________________________________________
___ Other hematologic problems
If indicated above, please describe: _____________________________________________________________
Cancer or Cancer Treatment
___ NO cancer or cancer treatment
___ Cancer: When? _________________________________ What Kind? ________________________________
___ Chemotherapy/radiation When? ________________________ What Kind?
____________________________
If indicated above, please describe: _____________________________________________________________
Have you ever been hospitalized? If YES, When/What For: ____________________________________________
___________________________________________________________________________________________
___________________________________________________________________________________________
Have you visited the emergency room in the last 5 years? If YES, describe: ________________________________
___________________________________________________________________________________________
___________________________________________________________________________________________
*For Females only:
Is it possible you are pregnant?
___ No
___ I am pregnant, expected due date: _________________________________
Are you currently breast feeding?
___ No
___ Yes
Do you have any disease, condition or problem not listed above of which we should be aware?
___ None
___ YES, describe: ____________________________________________________________________________
___________________________________________________________________________________________
___________________________________________________________________________________________
3
� Adult Health History
Chart #: ________________
Please list all prescribed medications.
Prescribed Medications Dosage Frequency
Over‐the‐Counter Dosage Frequency
Please list all supplements, herbal medications, and homeopathics taken:
Supplements/Herbs Dosage Frequency
4
� Adult Health History
Chart #: ________________
Have you received or are you scheduled to receive bisphosphonates drugs. (i.e: Zometa, Aredia, Fosamax) for bone
cancer or severe osteoporosis? If YES, describe ___________________________________________________________
_____________________________________________________________________________________________________
_____________________________________________________________________________________________________
Have you received or are you scheduled to receive intravenous bisphosphonates drugs. (i.e: Didronel, Boniva,
Actonel or Skelid) or other bone preserving drugs (ie: Denosumab) for osteoporosis?
If YES, describe: ______________________________________________________________________________________
_____________________________________________________________________________________________________
Recreational Drugs
___ No recreational drugs
___ Alcohol
___ Tobacco
___ Cannabis / Marijuana
___ Other recreational drugs: _________________________________________________________________________
Are you currently under the care of a physician, or have you been treated by a physician in the past? _____ No
_____ Yes. When was the last visit? ___________________________________________________________________
Please describe: _______________________________________________________________________________
Are you seeing any of the following specialist physicians?
___ Cardiologist Provider / Clinic Name: _________________________________________________________
Provider Phone: _______________________________________________________________
___ Endocrinologist Provider / Clinic Name: _________________________________________________________
Provider Phone: _______________________________________________________________
___ Oncologist Provider / Clinic Name: _________________________________________________________
Provider Phone: _______________________________________________________________
___ Pulmonologist Provider / Clinic Name: _________________________________________________________
Provider Phone: _______________________________________________________________
___ Neurologist Provider / Clinic Name: _________________________________________________________
Provider Phone: _______________________________________________________________
___ Other, Specialty Type: ____________________________________________________________________________
Provider / Clinic Name: ______________________________________________________________________
Provider Phone: _____________________________________________________________________________
Do you require premedication for dental treatment? If YES, describe: ________________________________________
_____________________________________________________________________________________________________
Has the premedication been prescribed by a physician or other healthcare provider? ___ YES ___ NO
If YES, provide the Provider Name: ______________________________________________________________
Provider Phone: _______________________________________________________________________________
Provider Address: _____________________________________________________________________________
Provider and Pharmacy Information
Primary Care Provider or Physician’s name: ______________________________________________________________
Provider Phone: _______________________________________________________________________________
Provider Address: _____________________________________________________________________________
Preferred Pharmacy name: _____________________________________________________________________________
Pharmacy Phone: ______________________________________________________________________________
5
� Adult Health History
Chart #: ________________
Social History
Upon request, a Social Worker can be assigned to assist you with some unmet needs in your life. Please answer
the following questions to identify if this is something you would like.
Are you experiencing difficulty due to unmet needs in any of the following areas of your life?
Please check all that apply
___ No
___ Employment/Income limitations
___ Mental health
___ Drug use
___ Alcohol use
___ Physical health issues with no primary care medical provider
___ Family (death, divorce, domestic violence, etc.)
Will any of the following make it difficult to complete dental care? Please check all that apply
___ No
___ Fear or anxiety
___ Lack of housing
___ Inadequate food
___ Lack of time
___ No transportation
___ Lack of funds/cost of treatment
___ Other: ___________________________________________________________________________________________
_____________________________________________________________________________________________________
If you selected any of the choices in the previous two questions, would you be willing to meet with one of our
social work team members?
___ No
___ Yes
6
� Adult Health History
Chart #: ________________
Dental History
Have you seen a dentist in the last five years?
___ No
___ Yes, my last visit was for: ___________________________________________________________________________
Why are you seeking dental care now? (Chief Complaint)
_____________________________________________________________________________________________________
_____________________________________________________________________________________________________
What is your long‐term goal for your mouth? _____________________________________________________________
_____________________________________________________________________________________________________
_____________________________________________________________________________________________________
Please review the following list and check all that apply:
___ I have immediate concerns.
___ I am presently in pain.
___ I have had periodontal treatment/surgery.
___ My gums feel tender or irritated.
___ I avoid parts of my mouth while brushing.
___ My gums bleed while brushing my teeth.
___ Food catches between my teeth.
___ There is a bad taste or odor in my mouth.
___ I may have a growth or swellings in my mouth.
___ I have frequent cold sores, canker sores or fever‐blisters on my gums, cheeks or lips.
___ I have noticed tooth mobility and or looseness.
___ I have had an unusual or bad reaction to dental anesthetic.
Please describe: ______________________________________________________________________________________
___ I have had my teeth professionally cleaned.
If YES, how often ______________________________________________________________________________
___ I have received instruction on how to clean my teeth.
What toothpaste, floss, and/or water‐pik do you use? _____________________________________________________
_____________________________________________________________________________________________________
___ I am dissatisfied with the appearance of my teeth.
___ I am unhappy with my smile.
___ I am frustrated with the need for constant dental treatment because of active dental disease.
___ I have had serious trouble associated with previous dental treatment.
___ I am anxious about dental treatment.
___ I am concerned about the finances required for excellent dental health.
___ I want to learn to control my dental disease to preserve my teeth and oral health.
7
� Adult Health History
Chart #: ________________
TMJ and Jaw Joint Pain History
Have you had pain or stiffness in your jaw or temple in the last thirty days?
___ No pain
___ Pain comes and goes
___ Pain is always present
___ Stiffness in jaw on awakening
Do the following activities make the jaw or temple pain better or worse on either side?
___ Chewing hard or tough food
___ Opening your mouth or moving your jaw to the side
___ Clenching, grinding, chewing gum, or holding your teeth together
___ Talking, kissing, or yawning
Please review the following list and check all that apply:
___ I have chronic headaches.
___ I have chronic neck pain.
___ I am aware of my jaw popping, clicking or making noises.
___ I sometimes have pain or ringing in your ears.
___ I am aware of clenching my teeth during the day.
___ I have been told that I grind my teeth at night.
___ I awaken with an awareness of my teeth or jaws.
___ I have trouble with opening my mouth widely.
___ My jaw sometimes locks open or closed.
___ I sometimes feel my bite is different, unstable, or uncomfortable.
___ I have sought treatment for a TMJ problem.
___ My jaw affects my ability to chew.
___ None of the above